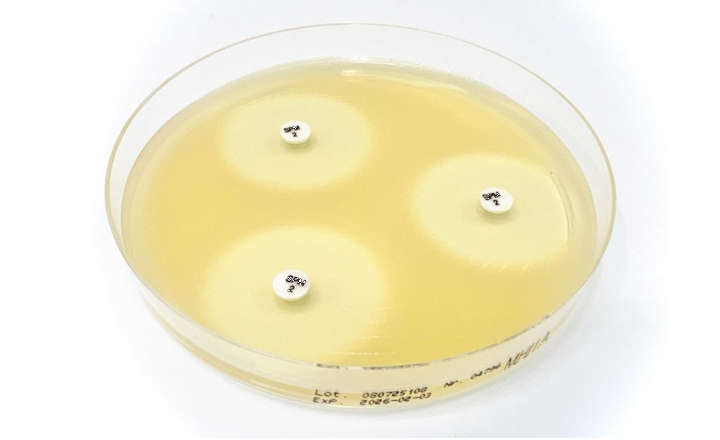
Assess Susceptibility of Enterobacterales With US FDA-cleared Sulopenem Disc SPM 2&micro;g

Transform your microbiology lab with this rapidmicrobiology special focus on rapid detection solutions for waterborne pathogens.
From our new Journal Club pages, read about the results of a recent study comparing six ISO 11731:2017 standardized culture techniques for detecting Legionella in 276 hospital hot-water samples. Which one came out best?
MICA Advance Legionella is a rapid, culture-based detection solution that brings Legionella pneumophila results significantly faster. The workflow follows familiar Legionella testing steps with early detection and automatic counting of Legionella pneumophila microcolonies on the membrane by the MICA Advance instrument, reported as CFU/L.
Redipor, part of AnalytiChem, offers reliable, ready-to-use media for testing waterborne pathogens. Key benefits include proven reliability with products like Plate Count Agar and MacConkey Agar, extended shelf life of up to 112 days, and rapid identification through chromogenic and selective media. Redipor also provides customizable formats to suit specific lab needs.
AquaCHROM™ ECC, a chromogenic medium for detecting E. coli and coliform bacteria, is AOAC-certified, delivers results in 18–24 hours, and features high sensitivity and specificity, making it ideal for routine water quality monitoring.
Detect Pseudomonas aeruginosa faster than ever with Bio-Rad’s RAPID’P.aeruginosa chromogenic medium. Specially formulated for challenging water samples such as bottled water, well water, lakes, and streams, the medium selectively inhibits most interfering microorganisms, including other Pseudomonas, whose colonies appear transparent or yellow.
Hygiena’s foodproof® Norovirus (GI, GII) plus Hepatitis A Virus Detection Kit is a robust 'all-in-one' solution allowing laboratories to simultaneously detect and differentiate between Norovirus Genogroups I & II and Hepatitis A in a single real-time RT-PCR reaction.
For wastewater samples, the WATCHFIRE™ R Panel is a unique multiplex 22-target PCR test that detects nucleic acids of common respiratory viruses and bacteria* shed in faeces and detectable in wastewater samples in about 45 minutes.
Foodborne Cryptosporidium outbreaks remain largely undetected due to technical challenges in environmental testing. Our new Journal Club highlighted some work that provides a validated, field-ready molecular toolkit for integrated monitoring of protozoan pathogens within the water–soil–plant–food nexus. By enabling harmonized detection from source water to edible crops, the approach offers a practical foundation for risk reduction strategies in produce production and irrigation management.
Plus, there are two recorded, on-demand webinars, one from Diamidex on getting E.coli CFU counts within 6 hours and one from ThermoFisher Scientific for ISO 17025-accredited water testing labs, covering the latest updates and how to keep compliant.
Find Out More
Find Out More
Find Out More
Find Out More
Find Out More
Find Out More
Find Out More
Find Out More
Find Out More
Find Out More
Find Out More
Find Out More